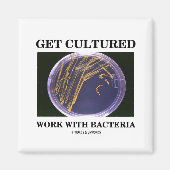
Aimant Get Cultured Work With Bacteria (Devant)

A propos de Magnets
Vendu (e) par
À propos de ce design
Aimant Get Cultured Work With Bacteria
Montrez votre sens de l'humour bactérien avec n'importe lequel de ces dons mettant en vedette des bactéries sur une plaque d'agar, ainsi que le truisme scientifique disant "Obtenez un travail de culture avec les bactéries". Pas besoin d'être anthropologue ou biologiste pour comprendre cette double signification impliquant la culture bactérienne !
Traduction automatique
Avis des clients
5.0 sur 5 étoiles6 Nombres de Commentaires
6 Commentaires
Avis sur des produits similaires
5 sur 5 étoiles
Par Michel R.30 avril 2021 • Achat sécurisé
Aimant, Style : Magnet rond, Taille : Standard, 5,7 cm
Programme d'évaluation de Zazzle
C'est génial et très mignon. Excellent très bonne qualité
5 sur 5 étoiles
Par Ph D.25 avril 2021 • Achat sécurisé
Aimant, Style : Magnet rond, Taille : Standard, 5,7 cm
Programme d'évaluation de Zazzle
Difficile d'écrire trois tonnes de commentaires sur un magnet ... le nombre d' étoiles choisi devrait suffire à la peine ! Cinq étoiles > excellente aussi, l'impression.
5 sur 5 étoiles
Par Ph D.8 mai 2021 • Achat sécurisé
Aimant, Style : Magnet rond, Taille : Standard, 5,7 cm
Programme d'évaluation de Zazzle
Très, très, très, très bien. < 4 x 'très' pour faire 20 caractères
Tags
Autres infos
Identifiant du produit : 147565088595192425
Fabriqué le 30/03/2011 6:58
Évalué G
Articles vus récemment